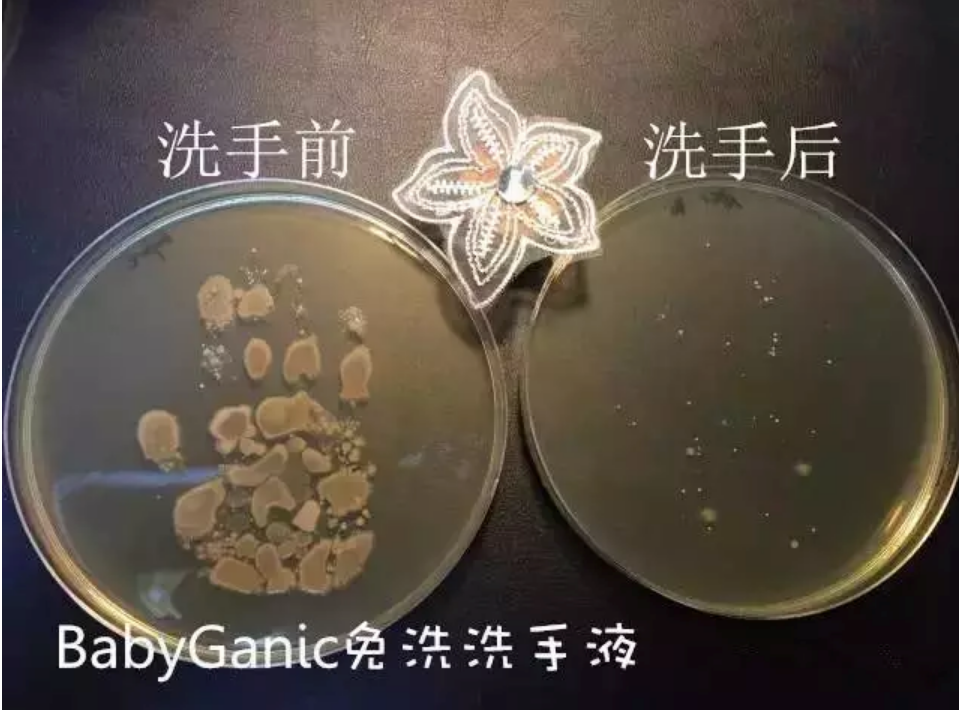
甘尼克寶貝babyganics免洗洗手液寶寶多大可以用 babyganics免洗洗手液好不好

時間:2018-04-26 18:32:02來源:本站整理作者:liliang點擊:
馬上就五一小長假了,出行的好時光,每次出行,不管是長途旅行,還是去公園,早教中心或者超市,餐廳,媽咪包里總是少不了這件神器。那就是免洗洗手液,畢竟很多的寶寶喜歡把手放進嘴里,但是長途旅行沒有那么方便,免洗洗手液就是最好的選擇了。下面八寶網的小編為大家分享甘尼克寶貝babyganics免洗洗手液寶寶多大可以用,babyganics免洗洗手液好不好大家一起來看吧。

植物配方,安全無毒,綠色環保,新生兒都能用
平常我們用的清潔用品,大部分采用化學合成原料,甘尼克寶貝babyganics用的是天然植物原料,比如大豆、椰子、棕櫚仁和糖分中提取有效的清潔成分,不含酒精、色素、毒素、污染源、人工香料等、無腐蝕性、無有害化學成分和填充劑。可以生物降解,也不會破壞環境。

小朋友觸摸、吸入甚至吞咽都是沒有問題的。即使是新生兒、敏感肌寶寶,也可以用。
而且那么多品牌研究下來,只有甘尼克敢說自己是可以喝的。

它的創始人,真的是直接喝洗手液的。經常各種場合,一言不合就喝上了。(請勿模仿哦)

別看兩位奶爸長得五大三粗,自從有了孩子他們就變身超級大潔癖,他們尋遍美國各大超市賣場,只為找出一款純天然,無毒并且不會污染環境的寶寶清潔用品。
很遺憾他們沒有找到,因此他們決定自己造。
奶爸Kevin說:我們對“清潔”的定義是:沒有化學氣味,沒有化學殘留,用我們的產品清潔過的表面可以直接接觸入口食物。
奶爸Keith說:有人叫我們清潔怪胎,說我們患上了清潔強迫癥。是的,我們熱愛清潔,達到了偏執的程度。我們甚至像勇士一樣喝了一些我們所配制的清潔藥水。
就是這種近乎瘋(bian)狂(tai)的精神造就了現在的甘尼克寶貝——
獲母嬰界的奧斯卡獎
清潔用品被稱為全球唯一“可以喝的清潔劑”
是美國高端母嬰商場的銷量保證
美國幼兒園和學校指定日常清潔用品
……

如果覺得創始人的故事還不足夠說服你,那丹媽要搬出美國權威的EWG來說說它的安全性了。
美國環境工作組(Environmental Working Group,簡稱EWG)是設在華盛頓的一個非營利、非黨派的民間環保組織,成立于1993年,致力于產品檢測和評級。
它重視環保,而且其資金主要來源于私人基金會,所以它敢于直言、披露危害環境和人類健康的行為。美國EWG評級是從產品的成分構成出發反映了潛在的健康危害,指標體現的是該產品成分構成的關注相對水平,而不針對產品本身,該評級不考慮曝光或個體易感性的決定因素實際的健康風險。所以在全世界人民對這個機構的檢測特別信服!

我們知道EWG的評級中,分數越小越安全,而1分是最高等級的。

甘尼克寶貝的評級1分,足以說明它的安全性。
可以說,能通過EWG檢測的洗手液,孩子洗完干手之后,是可以直接進食的,很安全。
這瓶超大的補充裝一共有473ml哦,足足能頂9瓶便攜裝。


每次便攜裝里的洗手液用完之后,就可以用補充裝再把它灌滿。
一個473ml的補充裝+一個50ml的便攜裝,相當于買了10個便攜裝的免洗洗手液,平均一瓶的價格還不到15元。

網友跟帖
Copyright 2015-2020 8bb.com 〖八寶網〗 版權所有 鄂ICP備19016373號-1
聲明: 本站文章均來自互聯網,不代表本站觀點 如有異議 請與本站聯系 本站為非贏利性網站 不接受任何贊助和廣告
網友評論僅供其表達個人看法,并不表明八寶網立場。